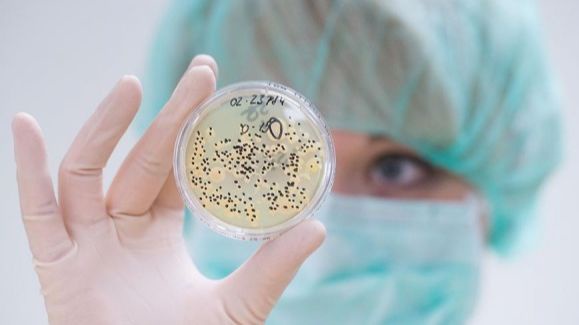

Обычно он не вызывает заболевания людей, а является мощным аллергеном, но в случаях очень глубокого иммунодефицита может в единичных случаях проявляться как оппортунистическая инфекция. В силу природно-географических факторов этот микоз потенциально более актуален для стран Юго-Восточной Азии, сообщает ТАСС со ссылкой на пресс-служба Роспотребнадзора.
В ведомстве пояснили, что "черная плесень" распространена практически во всех странах, она выявляется под обоями, в углах и супервлажных помещениях. Большая концентрация спор этого микоза именно в Индии объясняется огромной влажностью и высокой среднегодичной температурой.
Еще до пандемии мукормикоз был распространен в Индии больше, чем в других странах, в основном из-за большого числа больных диабетом. В настоящее время в стране участились случаи обнаружения мукормикоза у пациентов, инфицированных коронавирусом. Индийские СМИ сообщают о растущем числе заболеваний мукормикозом в штате Махараштра и его столице Мумбаи, в штате Гуджарат и ряде других регионов. О точном числе заболевших "черной плесенью" пока не сообщается, но врачи отмечают, что в отдельных клиниках наблюдается рост более чем в два раза, есть и смертельные случаи.